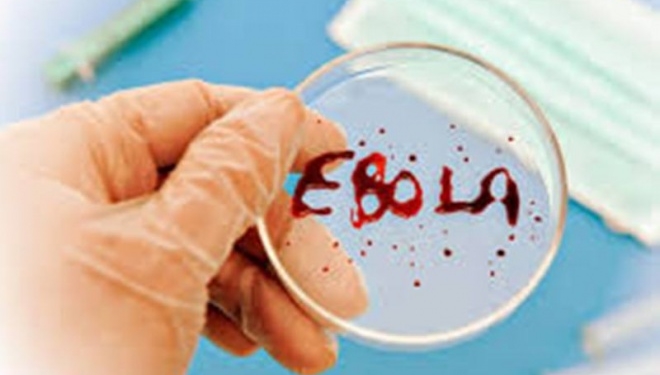
Чим небезпечний вірус Ебола

Хвороба, спричинена вірусом Ебола – смертельно небезпечне захворювання, що реєструється на території країн Західної та Центральної Африки, де існують ендемічні вогнища цієї хвороби.
У 2014 році масштабний спалах гарячки Ебола охопив Гвінею, С’єра-Леоне, Ліберію та Нігерію.
За даними Всесвітньої організації охорони здоров’я (ВООЗ), за період 2016 року було зареєстровано 11 тисяч 316 смертей внаслідок хвороби Ебола, загалом випадків цієї хвороби зареєстрували 28 тисяч 639 за час останнього її спалаху, що почався у 2014 році. Найбільше були уражені країни Західної Африки. Епідемія особливо важко позначилася на дітях. У Ліберії, Гвінеї та Сьєрра-Леоне приблизно 23 тис. дітей або втратили одного з батьків, або стали круглими сиротами.
Можливість виникнення захворювання на території Європи та України низька. Однак існує високий ризик зараження громадян при перебуванні на територіях Західної та Центральної Африки.
На території країн Африки інфікування людей відбувається при безпосередньому контакті з інфікованими кажанами, гризунами або приматами під час відлову, розтину, приготування їжі з м’яса цих тварин та використанні продуктів, що можуть бути забруднені їх виділеннями (слина, сеча, фекалії та ін.). Хвороба також передається від людини до людини. Передача вірусу від хворої людини відбувається через:
• медичне обладнання, інструментарій, посуд, предмети побуту, одяг, білизну, санітарно-технічні засоби, інвентар та інші об’єкти забруднені виділеннями хворого;
• ін’єкції та маніпуляції, які порушують цілісність шкіри та слизових оболонок;
• статевий контакт.
Прихований період (період без проявів клінічних симптомів) може становити від 2 до 21 дня з моменту інфікування.
Хвороба починається гостро з підвищення температури тіла до 38–390С, що може супроводжуватися сильним головним болем, появою сухості та першіння у горлі, нудотою та загальною слабкістю. У подальшому з’являються крововиливи у шкіру, кровотечі з носа, ясен, кров у випорожненнях, «криваве» блювання.
Для надання своєчасної медичної допомоги при появі будь-яких симптомів захворювання необхідно негайно звернутися за медичною допомогою, обов’язково попередити лікаря про перебування протягом попередніх 21 діб у країнах Західної та Центральної Африки.
У разі відвідування країн Західної та Центральної Африки, необхідно дотримуватись наступних запобіжних заходів:
• регулярно дотримуватись заходів особистої гігієни;
• уникати контакту з хворими людьми;
• уникати участі у ритуальних обрядах;
• уникати контакту з кров’ю та біологічними рідинами будь-якої людини, особливо тих, хто хворіє;
• уникати контакту з живими та мертвими тваринами (кажанами, приматами, гризунами, антилопами, дикобразами, свинями);
• вживати безпечні продукти харчування (термічно оброблені, ретельно вимиті).
Читайте також: За “двісті гривень” молодик обікрав свого сусіда
Всесвітня організація охорони здоров’я заявила про винайдення ефективної вакцини проти смертельного вірусу Ебола. Проведена в західноафриканській країні Гвінеї експертиза підтвердила високу ефективність експериментальної вакцини. За даними ВООЗ, після щеплення вакциною rVSV-ZEBOV майже у шести тисяч людей упродовж 10 днів спостереження не було зафіксовано жодного нового випадку захворювання. Вакцинували осіб, які перебували в тісному контакті з хворими. У ВООЗ також зазначили, що вакцина повинна отримати ліцензію вже до кінця 2017 року.
Лікар-епідеміолог Грабовська І.Я.